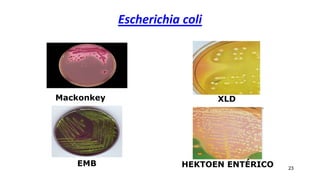
Escherichia coli
23
XLD
Mackonkey
EMB HEKTOEN ENTÉRICO

Este documento proporciona información sobre las enterobacterias. Brevemente describe: 1) Características generales de las enterobacterias como su morfología, metabolismo y patogenicidad; 2) Las islas de patogenicidad que contienen genes de virulencia en estas bacterias; y 3) Algunos de los principales patotipos de Escherichia coli y sus factores de virulencia asociados, incluyendo E. coli enterotoxigénica, enteroagregativa y enteropatogénica.